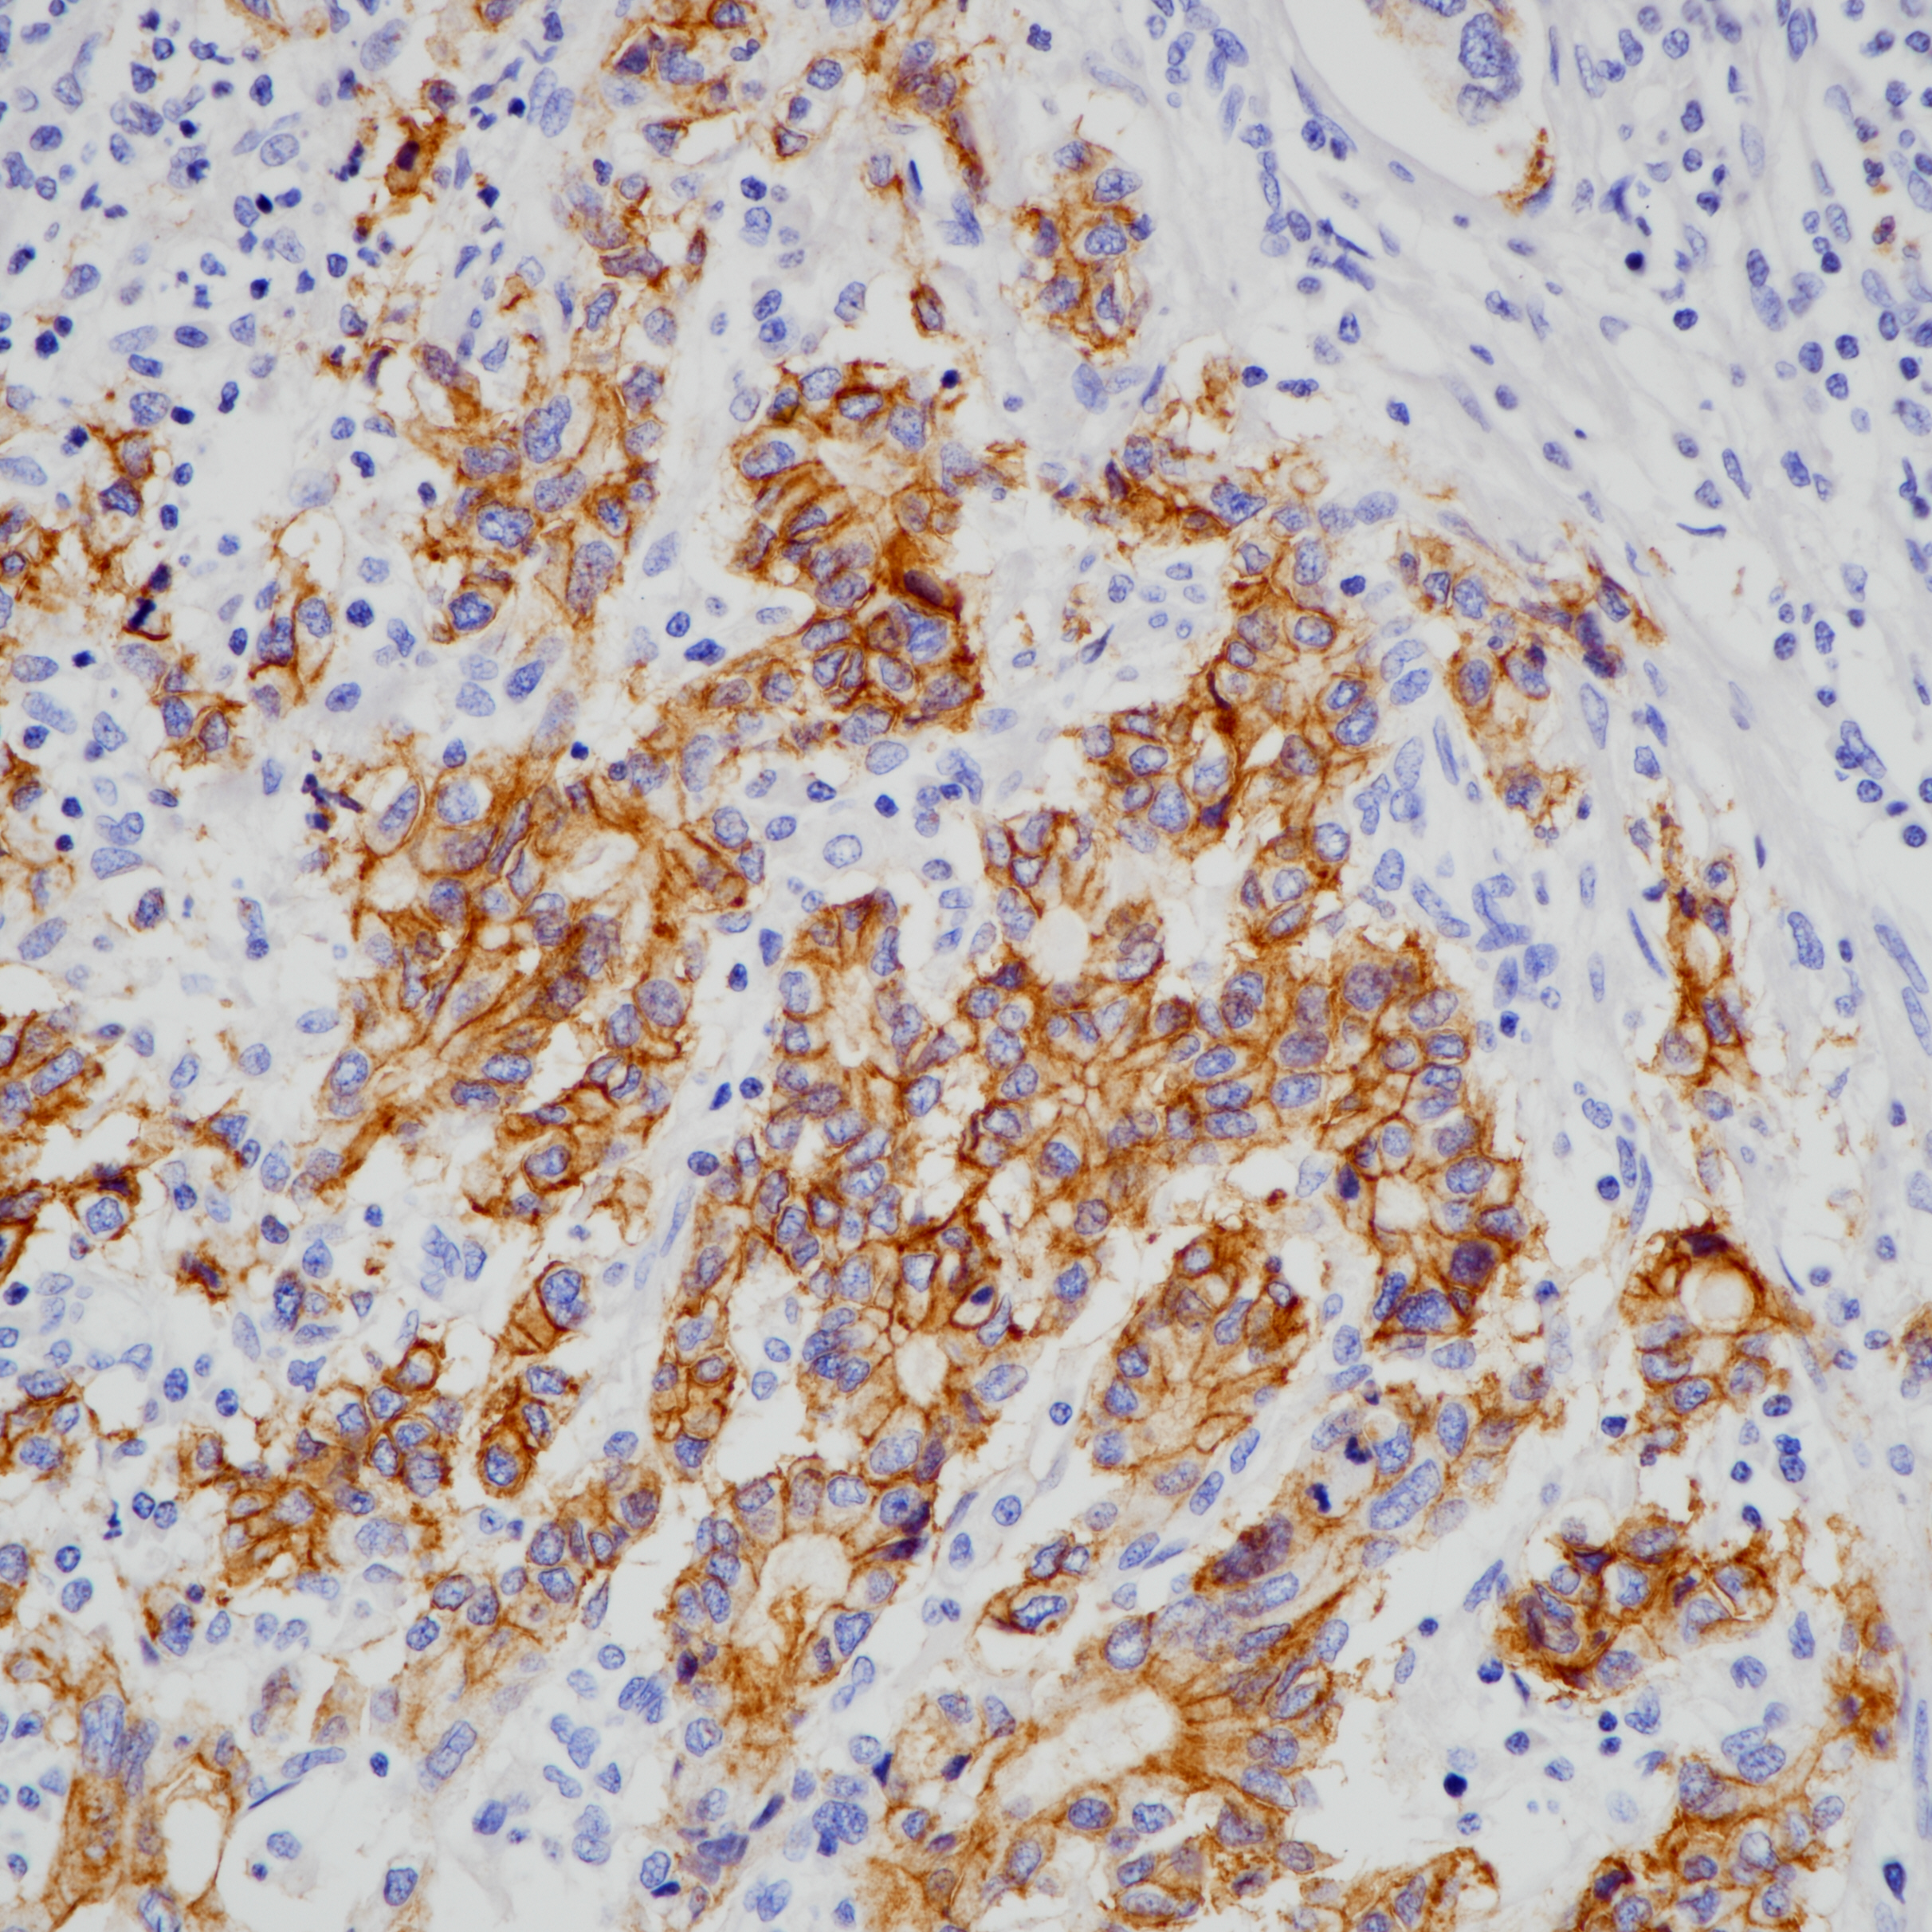
胃癌CLDN18.2(BP6249)染色

1. Clinical Implications of Claudin18.2 Expression in Patients With Gastric Cancer. [J] . Baek Jin Ho,Park Dong Jin,Kim Gyu Yeol,Cheon Jaekyung,Kang Byung Woog,Cha Hee Jeong,Kim Jong Gwang. Anticancer research . 2019 (12)
2. Expression of the potential therapeutic target claudin-18.2 is frequently decreased in gastric cancer: results from a large Caucasian cohort study. [J] . Dottermusch Matthias,Krüger Sandra,Behrens
Hans-Michael,Halske Christine,R?cken Christoph. Virchows Archiv : an international journal of pathology . 2019 (5).
3. Comparison of Claudin 18.2 expression in primary tumors and lymph node metastases in Japanese patients with gastric adenocarcinoma. [J] . Rohde Christoph,Yamaguchi Rin,Mukhina Svetlana,Sahin Ugur,Itoh Kyogo,Türeci ?zlem. Japanese journal of clinical oncology . 2019 (9).